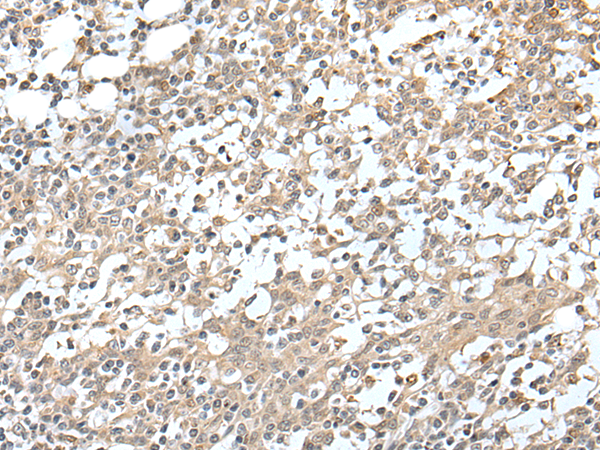
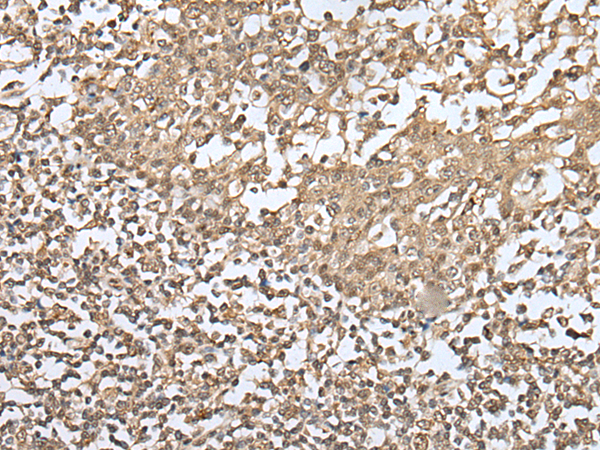
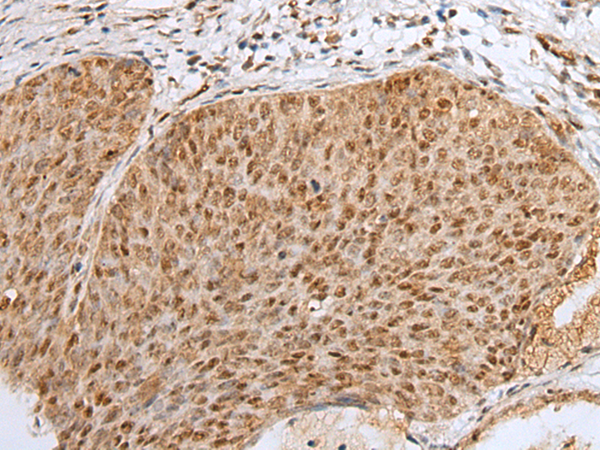

-
分类: 科研抗体货号: P09226别名: KOX12应用: IHC反应种属: Human
-
分类: 科研抗体货号: P09228别名: ZSCAN42; ZKSCAN10应用: IHC反应种属: Human
-
分类: 科研抗体货号: P09242别名: MRX89应用: IHC反应种属: Human
-
分类: 科研抗体货号: P09225别名: ZBTB35; pHZ-10应用: WB,IHC反应种属: Human, Mouse, Rat
-
分类: 科研抗体货号: P09241别名: KOX21; ZNF37应用: IHC反应种属: Human
-
分类: 科研抗体货号: P09223别名: KOX18; ZNF36; PHZ-37; ZNF139; ZSCAN33; 9130423L19Rik应用: WB,IHC反应种属: Human, Mouse, Rat
-
分类: 科研抗体货号: P09240别名: EZNF; HKL1; KID1; KID-1; TCF17; HEL104应用: IHC反应种属: Human, Mouse, Rat
-
分类: 科研抗体货号: P09222别名: pHZ-32应用: IHC反应种属: Human
-
分类: 科研抗体货号: P09239别名: KOX32应用: IHC反应种属: Human
-
分类: 科研抗体货号: P09221别名: SR3; DFCP1; TAFF1; ZNFN2A1; PPP1R172应用: WB,IHC反应种属: Human, Mouse

鄂公网安备42018502007531号
鄂公网安备42018502007531号

